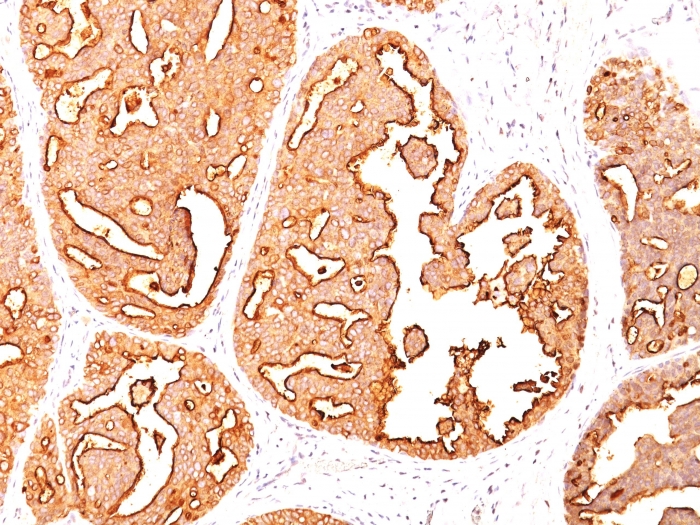
产品封面图

相关产品推荐更多 >
万千商家帮你免费找货
0 人在求购买到急需产品
- 详细信息
- 文献和实验
- 技术资料
- 免疫原:
Human milk-fat globule membranes (HMFGM)
- 亚型:
IgG1, Kappa
- 形态:
Liquid
- 保存条件:
Store as concentrated solution. Centrifuge briefly prior to opening vial. For short-term storage (1-2 weeks), store at 4℃. For long-term storage, aliquot and store at -20℃ or below. Avoid multiple freeze-thaw cycles.
- 克隆性:
Monoclonal
- 标记物:
Unconjugated
- 适应物种:
Human
- 保质期:
12 months from the shipping date of the product.
- 抗原来源:
Human
- 目录编号:
GTX34854
- 级别:
Primary Antibodies
- 库存:
Available
- 供应商:
GeneTex
- 宿主:
Mouse
- 应用范围:
ICC/IF, IHC-P, FACS
- 浓度:
0.2 mg/ml(Please refer to the vial label for the specific concentration.)
- 靶点:
MUC1
- 抗体英文名:
MUC1 antibody [MUC1/967]
- 抗体名:
MUC1 抗体 [MUC1/967]
- 规格:
100 μg
IHC-P analysis of human endometrial carcinoma tissue using GTX34854 MUC1 antibody [MUC1/967].
IHC-P analysis of human ovarian carcinoma tissue using GTX34854 MUC1 antibody [MUC1/967].
IHC-P analysis of human breast carcinoma tissue using GTX34854 MUC1 antibody [MUC1/967].
风险提示:丁香通仅作为第三方平台,为商家信息发布提供平台空间。用户咨询产品时请注意保护个人信息及财产安全,合理判断,谨慎选购商品,商家和用户对交易行为负责。对于医疗器械类产品,请先查证核实企业经营资质和医疗器械产品注册证情况。
文献和实验Isolation of Human Fab Fragments Against Ovarian Carcinoma Using Guided Selection
on aspects such as mechanisms of action, preclinical screening, and clinical results, see specific references in Table 1 and an excellent recent review (1 ). Table 1 Target Antigens Potentially Suited for Antibody-Based Immunotherapy of Ovarian
-7、Siglec-8、Siglec-9、Siglec-10、Siglec-11、Siglec-XⅡ、Siglec-14、Siglec-16 这类成员进化速率较快,因此也叫作快速进化型。主要分布于髓系细胞(中性粒细胞、单核细胞、巨噬细胞)。其胞内段通常含有免疫受体酪氨酸抑制基序(ITIM)或 ITIM 样基序,配体结合后通过招募磷酸酶 SHP-1/2 传递抑制信号,从而发挥“免疫刹车”作用。 值得注意的是,部分成员如 Siglec-14 和 Siglec-15,其跨膜区含有带正电荷的氨
多篇 SCI 发现用 RIPA 提蛋白存在问题,我们该如何应对?
公司把它变成了现实,来自美国专利技术离心管柱蛋白提取法,只需您加入裂解液,过柱离心,不产生不可溶组分,1 分钟轻松解决蛋白提取丢失问题。参考文献Alcaraz, C, et al. (1990) . Comparison of a radioimmunoprecipitation assay to immunoblotting and ELISA for detection of antibody to African swine fever virus. J. Vet. Diagn
技术资料暂无技术资料 索取技术资料

![Hexokinase II antibody [4C5]](https://img1.dxycdn.com/2022/0328/915/5855206428348500453-14.jpg!wh200)





